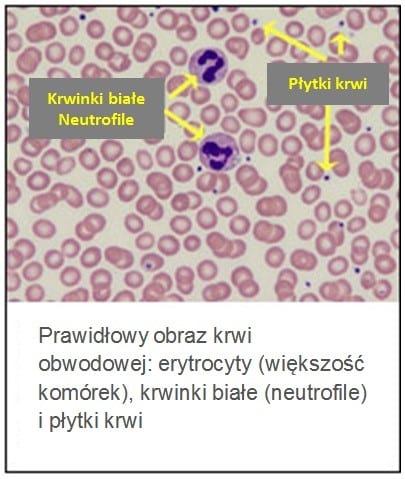

W skrócie
W jakim celu badanie jest wykonywane?
Badanie jest wykonywane w celu oceny zmian liczby krwinek czerwonych; wykorzystywane do wykrywania, rozpoznawania i monitorowania zaburzeń i chorób, które mają wpływ na krwinki czerwone.
Kiedy badanie jest wykonywane?
Badanie jest wykonywane jako część badania morfologii krwi w ramach badań okresowych lub przy podejrzeniu występowania niedokrwistości (zmniejszenie liczby erytrocytów) lub nadkrwistości (zwiększenie liczby erytrocytów).
Jak się pobiera próbkę do badania?
Krew pobiera się z żyły łokciowej lub nakłucia opuszki palca (dorośli i dzieci) lub pięty (noworodki).
Czy do badania trzeba się przygotować?
Nie.
Informacja o próbce
Co się oznacza?
Dzięki uprzejmości Betty Jamieson
Krwinki czerwone (RBC, erytrocyty) są komórkami, które wraz z krwią krążą w organizmie i przenoszą tlen. RBC to liczba erytrocytów w próbce krwi pobranej od pacjenta. RBC jest jednym z parametrów badania o nazwie morfologia krwi obwodowej, które jest bardzo często wykonywane w ramach ogólnej oceny stanu zdrowia.
W skład krwi wchodzi kilka typów komórek, w tym krwinki czerwone (RBC), krwinki białe (WBC) i płytki krwi (PLT), które są zawieszone w płynnej części krwi, czyli osoczu. RBC są wytwarzane w szpiku kostnym i uwalniane do krwi po zakończeniu ich dojrzewania. RBC stanowią około 40% objętości krwi. Erytrocyty zawierają hemoglobinę, białko zdolne do wiązania tlenu. Głównym zadaniem erytrocytów jest przenoszenie tlenu z płuc do tkanek i narządów. Transportują także niewielkie ilości dwutlenku węgla, produktu metabolizmu komórek, z tkanek i organów do płuc, gdzie jest wydalany.
Czas życia erytrocytów wynosi około 120 dni, więc szpik kostny musi stale wytwarzać nowe krwinki, aby zastąpić te zniszczone lub utracone z powodu krwawienia. Na wytwarzanie nowych erytrocytów i czas ich życia w krążeniu ma wpływ wiele schorzeń, które mogą prowadzić do spadku RBC we krwi.
Zmniejszenie liczby erytrocytów pociąga zwykle za sobą spadek stężenia hemoglobiny i obniżenie hematokrytu. Spadek hemoglobiny poniżej wartości uznawanych za prawidłowe określa się jako niedokrwistość (anemię). Gdy stężenie hemoglobiny wzrasta powyżej górnej granicy przedziału referencyjnego mówi się o nadkrwistości. Kiedy erytrocytów we krwi jest zbyt mało zmniejsza się zaopatrzenie tkanek w tlen, a kiedy zbyt dużo krew ulega zagęszczeniu, co spowalnia przepływ krwi w naczyniach, co wywołuje problemy zdrowotne.
Badanie
W jakich przypadkach badanie jest wykonywane?
Oznaczanie RBC stanowi część badania morfologii krwi, które jest integralną częścią rutynowych badań kontrolnych, przeprowadzanych w celu wykrywania rozlicznych chorób. Badanie może być pomocne w rozpoznawaniu i monitorowania zaburzeń i chorób, które mają wpływ na wytwarzanie i czas życia erytrocytów.
Niektóre zaburzenia mogą wpływać na wytwarzanie erytrocytów w szpiku kostnym oraz uwalnianie dojrzałych erytrocytów do krążenia. Inne mogą skracać czas życia erytrocytów w krążeniu, szczególnie wtedy, gdy komórki te mają zmienioną budowę z powodu czynników wrodzonych lub nabytych. Nasilenie niszczenia RBC (hemoliza) lub utrata RBC (krwawienia) i/lub brak możliwości dostatecznie szybkiego wytwarzania RBC przez szpik kostny powodują spadek liczby RBC i stężenia hemoglobiny we krwi i rozwój niedokrwistości.
Badanie pozwala na wykrycie zaburzenia wytwarzania RBC i/lub skrócenia czasu przeżycia erytrocytów, ale nie na określenie przyczyny zaburzenia. Oprócz badania morfologii krwi wykonuje się dodatkowe badania, równocześnie lub po uzyskaniu wyniku morfologii, które mogą pomóc w ustaleniu podłoża zaburzenia. Są to m. in. rozmaz krwi obwodowej, liczba retykulocytów, wskaźniki gospodarki żelazem, witamina B12 i kwas foliowy, a w niektórych ciężkich schorzeniach badanie szpiku kostnego.
W jakich przypadkach badanie jest zlecane?
Badanie liczby RBC, jako część badania morfologii krwi, zleca się często w ramach rutynowych badań kontrolnych, u osób przygotowywanych do zabiegów chirurgicznych, a także u pacjentów wykazujących objawy wskazujące na zaburzenia dotyczące RBC, takie jak niedokrwistość lub nadkrwistość.
Do niektórych objawów niedokrwistości, które skłaniają lekarza do zlecenia badania morfologii, należą:
- Osłabienie lub zmęczenie
- Brak energii
- Omdlenia
- Bladość
- Przyspieszenie oddechu.
Do niektórych objawów nadkrwistości należą:
- Zaburzenia widzenia
- Zawroty głowy
- Bóle głowy
- Szum w uszach
- Powiększenie śledziony.
Badanie powtarza się regularnie u osób z rozpoznanymi chorobami krwi, z chorobami nerek, z krwawieniami lub z przewlekłą niedokrwistością lub nadkrwistością. Spadek czynności szpiku często wywołują także radio- i chemioterapia. U tych pacjentów badanie morfologii krwi należy do rutynowych badań wykonywanych w ramach monitorowania i oceny skuteczności leczenia.
Co oznacza wynik?
Ponieważ oznaczanie stężenia hemoglobiny jest częścią badania morfologii krwi, przy interpretacji badania bierze się równocześnie pod uwagę inne parametry, takie jak hematokryt, RBC, liczbę retykulocytów i/lub wskaźniki czerwonokrwinkowe. Należy także wziąć pod uwagę szereg innych czynników, w tym wiek, płeć, pochodzenie etniczne pacjenta.
Obniżenie liczby RBC może być skutkiem ostrych lub przewlekłych krwawień lub zaburzeń prowadzących do spadku wytwarzania erytrocytów w szpiku kostnym.
Niektóre przyczyny niskiej liczby RBC to:
- Uraz
- Ostre lub przewlekłe krwawienia z przewodu pokarmowego (np. obecność wrzodów, polipów, raka jelita grubego) lub innych miejsc jak pęcherz moczowy, macica (np. obfite krwawienia miesięczne) lub ciężkie urazy.
- Niedobory pokarmowe, m.in. żelaza, witaminy B12 lub kwasu foliowego
- Uszkodzenie szpiku kostnego przez, na przykład, toksyny, promieniowanie lub chemioterapeutyki, zakażenia lub leki.
- Zaawansowana przewlekła choroba nerek, która prowadzi do spadku wytwarzania erytropoetyny, hormonu produkowanego przez nerki, stymulującego powstawanie erytrocytów w szpiku kostnym.
- Przewlekłe zakażenia.
- Upośledzenie czynności szpiku kostnego z powodu takich chorób jak niedokrwistość aplastyczna, zespół mielodyspalstyczny lub nowotwory takie jak białaczki i chłoniaki lub inne nowotwory, które zajmują szpik kostny.
- Zwiększone niszczenie erytrocytów np. w niedokrwistości hemolitycznej spowodowanej obecnością autoprzeciwciał lub defektami budowy krwinek czerwonych. Do takich defektów należą hemoglobinopatie (np. w niedokrwistości sierpowatokrwinkowej), nieprawidłowości budowy błony RBC (np. we wrodzonej sferocytozie) lub zmiany aktywności enzymów krwinkowych (np. niedobór G6PD).
Podwyższona liczba RBC może być wynikiem:
- Czerwienicy prawdziwej, rzadkiej choroby, w której wytwarzana jest zbyt duża liczba erytrocytów
- Chorób płuc; jeśli z powodu trudności z oddychaniem dostarczana jest zbyt mała ilość tlenu organizm próbuje kompensować niedotlenienie wytwarzając większą liczbę RBC
- Wrodzonych chorób serca; w niektórych chorobach serce nie jest w stanie odpowiednio tłoczyć krwi, co powoduje zmniejszone zaopatrzenie tkanek w tlen. Organizm próbuje kompensować niedotlenienie wytwarzając większą liczbę RBC
- Nowotworów nerek, które wydzielają zwiększone ilości erytropoetyny
- Palenia tytoniu
- Długiego przebywania na dużej wysokości nad poziomem morza; jest to wynik kompensacji niższej zawartości tlenu w powietrzu wdychanym
- Przyczyn genetycznych (zmieniona wrażliwość na tlen, zaburzenia wiązania i oddawania tlenu przez hemoglobinę)
- Odwodnienia; jeśli zmniejsza się objętość płynnej części krwi liczba RBC pozornie się zwiększa
Uwaga
Dla wielu oznaczeń nie ustalono standardowych zakresów referencyjnych. Ze względu na to, że wartości te zależą od wielu czynników takich jak: wiek, płeć, badana populacja, metoda oznaczenia, wyniki przedstawione jako wartości liczbowe mają różne znaczenie w różnych laboratoriach. Wynik powinien zawierać zakres referencyjny dla konkretnego oznaczenia. Lab Tests Online zaleca, aby pacjent przedyskutował wyniki testu z lekarzem. Dodatkowe informacje na temat zakresów referencyjnych są dostępne w artykule:
Przedziały referencyjne i ich znaczenie.
Co jeszcze należy wiedzieć?
Liczba RBC zmienia się po przetoczeniu krwi.
Obniżenie liczby krwinek czerwonych ma miejsce w prawidłowej ciąży i jest wyrazem zwiększenia objętości płynu co prowadzi do rozcieńczenia krwi.
Osoby mieszkające w górach mają podwyższoną liczbę erytrocytów, co jest odpowiedzią na zmniejszająca się zawartość tlenu wraz ze wzrostem wysokości.
U kobiet liczba RBC jest zwykle nieco niższa niż u mężczyzn.
Pytania i odpowiedzi
- Jakie jest postępowanie w przypadkach stwierdzenia nieprawidłowej (obniżonej lub podwyższonej) liczby krwinek czerwonych?
Po pierwsze lekarz musi zidentyfikować przyczynę zaburzeń, a następnie zalecić leczenie, które może opierać się na zmianie sposobu żywienia, podawaniu witamin i składników mineralnych, a nawet przetoczeniu krwinek od dawcy. W wielu przypadkach wystarczająca jest zmiana przyjmowanych dotychczas leków lub podanie leków stymulujących produkcję erytrocytów w szpiku kostnym.
- Czy liczbę krwinek czerwonych można zbadać w warunkach domowych?
Nie. Badanie to może być wykonane tylko w warunkach laboratoryjnych przez wykwalifikowany personel.
- Czy odpowiednia dieta i prawidłowe odżywianie pomagają w utrzymaniu prawidłowej liczby erytrocytów?
Tak, stosowanie dobrze zbilansowanej diety może zapobiec niedokrwistości wywołanej niedoborem żelaza, witaminy B12 lub kwasu foliowego. W sytuacji możliwego niedoboru tych składników zaleca się przyjmowanie odpowiednich suplementów. Jednakże większość przypadków niedoboru witaminy B12 wynika z jej złego wchłaniania, a większość przypadków niedokrwistości z niedoboru żelaza jest spowodowana krwawieniami. W takich przypadkach, a także w zaburzeniach wywołanych innymi przyczynami niż niedobory pokarmowe, zmiana diety nie rozwiąże problemu.
- Czy istnieją objawy sugerujące nieprawidłową (obniżoną lub podwyższoną) liczbę krwinek czerwonych?
Do objawów, związanych z obniżeniem liczby erytrocytów można zaliczyć zmęczenie, omdlenia, bladość skóry, duszność i/lub zaburzenia emocjonalne. Natomiast zawroty głowy, zaburzenia świadomości mogą być wynikiem odwodnienia, dla którego charakterystyczne jest podwyższenie liczby krwinek czerwonych.
Źródła
UWAGA: Wymienione poniżej adresy stron internetowych, są źródłami uzupełniającymi. W celu obejrzenia kompletnej listy źródeł wykorzystanych w tworzeniu tej strony, kliknij tu.
Linki do stron polskich:
Niedokrwistość
Linki do stron obcojęzycznych:
American Society of Hematology: Blood Basics
ASH: Anemia
Mayo Clinic: High red blood cell count
MedlinePlus: Anemia